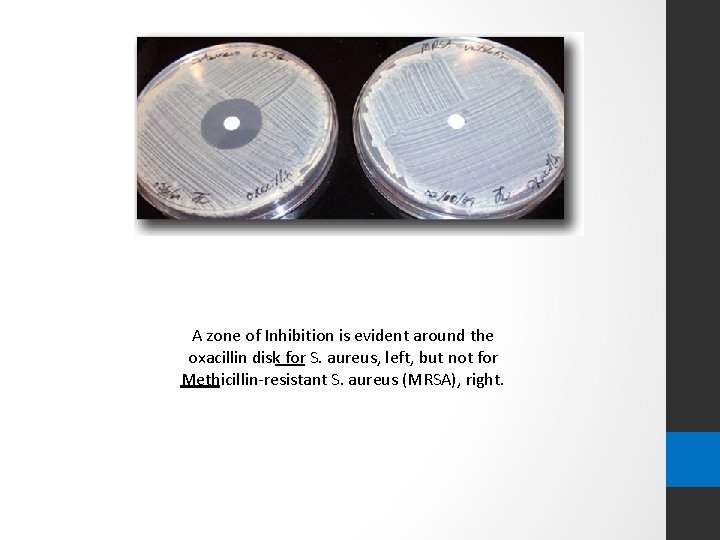
A zone of Inhibition is evident around the oxacillin disk for S. aureus, left,

Lab7 Quantitative Analysis of antigens by Radial Immunodiffusion
![Lab#7 Quantitative Analysis of antigens by Radial Immunodiffusion BCH 462 [practical] Lab#7 Quantitative Analysis of antigens by Radial Immunodiffusion BCH 462 [practical]](https://slidetodoc.com/presentation_image_h2/ad20247013ec76f72304d2cc86ea16f9/image-1.jpg)
Lab#7 Quantitative Analysis of antigens by Radial Immunodiffusion BCH 462 [practical]

Objective: -To get familiar with radial immunodiffusion. -To determine the concentration of unknown antigen.
![Antigen [Ag] molecules each have a set of antigenic determinants or epitopes. Antigen [Ag] molecules each have a set of antigenic determinants or epitopes.](http://slidetodoc.com/presentation_image_h2/ad20247013ec76f72304d2cc86ea16f9/image-3.jpg)
Antigen [Ag] molecules each have a set of antigenic determinants or epitopes.

Ag / Ab Precipitation reactions Polyclonal antibodies can form lattices, or large aggregates. However, monoclonal antibody can link only two molecules of antigen and no precipitate is formed. ( Lattices or large aggregates ) ( no precipitate is formed if an Ag contains only a single copy of each epitope )

Immunology/ Precipitation Reactions I- Precipitation in Solution Bottom Precipitate Ring Precipitate (Ring Test) II- Simple Immunodiffusion (ID) Double ID (Ouchterlony) Single Radial ID (RID) (Mancini) III- Electro-Immnodiffusion Immunoelectrophoresis (IEP) Immunofixation Rocket Electroimmunodiffusion (EID) Counterimmunoelectrophoresis (CIEP)

Precipitation Reactions: -Precipitation reactions are based on the interaction of antibodies and antigens. They are based on two soluble reactants that come together to make one insoluble product, the precipitate. -These reactions depend on the formation of lattices (cross-links) when antigen and antibody exist in optimal proportions. [ it is known as zone of equivalence and appears to us as precipitation].

Precipitation curve Plots of the amount Ag/Ab complexes precipitated when increasing Ag concentrations are added to constant concentration of Ab. It reveals 3 zones: 1. Zone of antibody excess - precipitation is inhibited antibody • not bound to antigen can be detected in the supernatant; 2. Zone equivalence - maximal precipitation in which antibody • and antigen form large insoluble complexes and neither antibody nor antigen can be detected in the supernatant; 3. Zone of antigen excess - precipitation is inhibited & Ag. not • bound to Ab. can be detected in the supernatant -Excess of either component reduces lattice formation and subsequent precipitation.

Precipitation Curve

Ring Precipitate (Ring Test) Bottom Precipitate

Simple Immunodiffusion (ID) Any technique involving diffusion of antigen or antibody through a semisolid medium, usually agar or agarose gel, resulting in a precipitin reaction. Objective : to determine the quantity ”concentration” of an antigen. -It is suitable for routine use in the diagnostic laboratories. a) Single Radial ID (Mancini Reaction) Ab is put into a gel and Ag is put in a well cut into the gel and a precipitin ring formed when Ag diffuses out in all directions. b) Double ID (Ouchterlony Reaction) Both Ab and Ag diffuse from wells into a gel medium

Principle of Single Radial ID (Mancini Reaction) is an immunodiffusion technique used in immunology to determine the quantity of an antigen by measuring the diameters of circles of precipitin complexes surrounding samples of the antigen that mark the boundary between the antigen, and an antibody fixed in a medium, such as an agar or agarose gel. The diameters of the circles increase with time as the antigen diffuses into the medium [which containing the fixed antibody], reacts with the antibody, and forms insoluble precipitin complexes [reach the zone of equivalence].

Determination of antigen concentration using radial immunodiffusion: 1. Incorporate of antiserum “antibodies” specific for the antigen of interest, into molten agarose. Then pour the mixture in Petri dish containing the uniformly distributed antiserum in the agarose gel.

2 - Cut the wells using a gel puncher. Then apply your standard antigen and sample antigen to the wells.

After the sample is added: - Initially, as the antigen diffuses through the well, its concentration is relatively high [So, no precipitation will occur]. -However, as antigen diffuses farther and farther from the well, its concentration decrease. -when its concentration becomes equivalent to that of the antibody fixed in the gel, A ring of antigen-antibody precipitate [ precipitin] is formed. [zone of equivalence] -the greater the initial concentration of antigen in the well, the greater the diameter of the precipitin ring. Antigen diffusion through the well radially.

Figure: Radial immunodiffusion test, antigen is filled in the well, antigen start diffusing radially in the gel containing specific antibody.

3. After 24 to 48 hour, the diameter of circular precipitates formed around the wells then they are measured. -By measuring the diameters of the precipitin rings formed by known antigen concentrations “standard antigens concentrations ”, a standard curve can be constructed. -the unknown antigen concentration, can then be found by simple interpolation having measured the diameters of the respective precipitin rings. Figure: The precipitin ring is formed around the wells of the samples. Note that: the diameters of precipitin rings are directly proportional to antigen concentration.

4. A plot of precipitation ring diameters versus concentrations is made for the samples with known antigen concentrations. 1 2 3 4 Figure: wells 1 -4 contain known standard concentrations of protein under study ”antigen”. The graph shows the resulting calibration curve from which, an unknown concentration of the antigen can be determent.

Simple Immunodiffusion Reactions The region of equivalence
![Zone of inhibition [Kirby-Bauer test method]: Zone of Inhibition test method is designed to Zone of inhibition [Kirby-Bauer test method]: Zone of Inhibition test method is designed to](http://slidetodoc.com/presentation_image_h2/ad20247013ec76f72304d2cc86ea16f9/image-19.jpg)
Zone of inhibition [Kirby-Bauer test method]: Zone of Inhibition test method is designed to test the ability of antimicrobial agents to inhibit the growth of microorganisms over an 18 -24 hour period of contact. Summary of Test: -A microbial suspension is spread by a sterile swab, evenly, over the face of a sterile agar plate. -The antimicrobial agent is applied to the center of the agar plate and incubated. -If substantial antimicrobial activity is present, then a zone of inhibition appears around the test product. The zone of inhibition is simply the area on the agar plate that remains free from microbial growth. -The size of the zone of inhibition is usually related to the level of antimicrobial activity present in the sample or product - a larger zone of inhibition usually means that the antimicrobial is more potent.
A zone of Inhibition is evident around the oxacillin disk for S. aureus, left, but not for Methicillin-resistant S. aureus (MRSA), right.
- Slides: 20